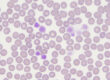
Laboklin: Makrothrombozyten, 1000-fache Vergrößerung, Immersionsöl, Giemsa-Färbung

Dass für Pferde eine gute Futterzusammensetzung und -qualität wichtig ist, ist inzwischen allgemein bekannt und so erfreuen sich Futtermittelanalysen großer Beliebtheit. Vergessen wird aber oft das Tränkwasser. Dabei ist die Bereitstellung von genügend Wasser in entsprechender Qualität essentiell, um Gesundheit und Leistungsbereitschaft der Pferde sicherzustellen.
Wasserbedarf
Allein für den Erhaltungsstoffwechsel werden durchschnittlich schon bis zu 5 l Wasser je 100 kg Körpergewicht benötigt – bei Stuten in der Laktation sogar die doppelte Menge. Auch andere Faktoren wie beispielsweise Arbeit, Temperament und Umgebungstemperatur lassen den Wasserbedarf ansteigen. Zu hohen Wasserverlusten kommt es bei Durchfall/Kotwasser oder Schwitzen.
Daher sollte Wasser rund um die Uhr zur Verfügung stehen. Bei Gruppenhaltung ist darauf zu achten, dass genügend Wasserstellen vorhanden und diese auch für rangniedere Tiere frei zugänglich sind. In der kalten Jahreszeit müssen die Tränken frostgeschützt sein. Die Funktion der Tränken (auch die Durchflussrate!) ist täglich zu überprüfen, denn kommt es zu einem Ausfall der Tränketechnik, müssen alle Pferde mindestens 3-, besser 5-mal täglich von Hand getränkt werden.
Wasserqualität
Für den menschlichen Trinkwassergebrauch ist die deutsche Trinkwasserverordnung rechtlich bindend. Für Tränkwasser gibt es keine gesetzlichen Vorgaben, sondern Orientierungswerte des Bundesministeriums für Ernährung und Landwirtschaft (BMEL) [BMEL: Hygienische Qualität von Tränkwasser, Orientierungsrahmen zur futtermittelrechtlichen Beurteilung, 2019]. Hierbei ist allerdings zu beachten, dass die Grenzwerte v.a. auf Nutztiere ausgelegt und nicht speziell für das Pferd erarbeitet worden sind. Da Pferde auf bestimmte Stoffe aber empfindlicher reagieren, müssen manche Richtwerte kritisch betrachtet werden.
Kriterien für die Eignung als Tränkwasser:
- Schmackhaftigkeit ist Voraussetzung für eine ausreichende Wasseraufnahme.
- Die Verträglichkeit gewährleistet, dass alle Inhaltsstoffe nur in einer für das Tier nicht schädlichen Konzentration enthalten sind.
- Die Verwendbarkeit berücksichtigt, dass sich keine nachteiligen Effekte auf die Tränketechnik ergeben dürfen.
Kontrolle der Wasserqualität
Sofern zum Tränken kein Wasser in Trinkwasserqualität verwendet wird, ist eine routinemäßige Wasseruntersuchung mindestens einmal jährlich empfehlenswert. Absolut notwendig ist sie spätestens bei Verdacht auf Verunreinigungen. Zu beachten ist, dass Wasser im Laufe des Jahres Veränderungen unterliegt. Wichtige Einflussfaktoren sind hierbei vor allem Niederschlagsmengen, Temperatur und Grundwasserspiegel.
Probenentnahme
Generell sollte die Wasserbeprobung unter sterilen Bedingungen erfolgen.
- Vor der Probenahme ist die Entnahmestelle möglichst durch Abflammen der Auslassöffnung zu sterilisieren. Alternativ kann der Zapfhahn auch für mehrere Minuten in eine Alkohollösung getaucht werden.
- Das eindeutig gekennzeichnete Probengefäß sollte steril sein, ggf. kann sich auch eine Mineralwasserflasche eignen.
- Wasser vor der Entnahme 2 – 3 Minuten laufen lassen.
- Kontaminationen vermeiden: Deckel erst unmittelbar vor Abfüllung abschrauben und unmittelbar danach verschließen, Innenseiten nicht berühren, ggf. Handschuhe tragen.
- Die benötigten Probenmengen können Sie dem Untersuchungsauftrag entnehmen, es sind je nach Untersuchung 0,7 – 1 l erforderlich. Transport: gekühlt, dunkel, so schnell wie möglich!
Die Tränkwasseruntersuchung
Mikrobiologische Parameter
Salmonellen, Campylobacter und E. coli sollten nicht nachweisbar sein. Salmonellen können beispielsweise durch Kot infizierter Tiere, v.a. Vögel, in das Wasser gelangen. Bei immunsupprimierten Pferden und Fohlen lösen sie mitunter schwere Durchfälle aus. Auch Campylobacter-Spezies kontaminieren das Wasser primär über Ausscheidungen kolonisierter Tiere (v.a. Wildvögel, Nutztiere, Hunde, Katzen). E. coli ist Bestandteil der physiologischen Darmflora bei Menschen und warmblütigen Tieren und gilt daher als Indikatorkeim für fäkale Verschmutzung.
Die Gesamtkeimzahl wird als Anzahl der koloniebildenden Einheiten (KBE) pro Milliliter angegeben und kann beispielsweise ansteigen nach Rohrbruch, Neuanschlüssen, langen Standzeiten oder auch bei veränderten Witterungsverhältnissen, wenn der Boden eine mangelnde Filtrationskraft aufweist. Bei jeder Änderung – spätestens jedoch bei Überschreiten der Orientierungswerte – sollte eine gründliche Ursachenforschung erfolgen.
| Parameter | Orientierungswert nach BMEL |
| Salmonellen | 0/100 ml |
| Campylobacter | 0/100 ml |
| E. coli | 0/100 ml möglichst weitgehend frei von E. coli |
| aerobe Gesamtkeimzahl bei 20 °C | < 10.000 KBE/ml |
| aerobe Gesamtkeimzahl bei 37 °C | < 1000 KBE/ml |
Quelle: BMEL: Hygienische Qualität von Tränkwasser. Orientierungsrahmen zur futtermittelrechtlichen Beurteilung
Weitere Parameter, für die das BMEL keine Orientierungswerte vorgegeben hat:
Coliforme Keime beinhalten verschiedene Bakteriengattungen, die zu den Enterobakterien bzw. zur Ordnung der Enterobacterales gehören. Diese Keime können fäkalen Ursprungs sein, sie können aber auch in der Umwelt vorkommen. Ihr Nachweis deutet daher nicht zwingend auf ein hygienisches Problem hin, sondern zeigt eher Mängel im Leitungsnetz an.
Enterokokken-Spezies sind wie E. coli Fäkalindikatoren. Gegenüber Umwelteinflüssen sind sie relativ resistent, daher kann ihr Vorkommen ein Hinweis auf länger zurückliegende Verunreinigungen sein.
Clostridium perfringens ist in offenen Gewässern (Seen, Flüsse) anzutreffen. Auf C. perfringens muss nur untersucht werden, wenn das Tränkwasser aus Oberflächenwasser gewonnen wird.
Pseudomonas aeruginosa ist ein Umweltkeim mit großer Anpassungsfähigkeit und Biofilmbildner. Sein Vorkommen erschwert die Beseitigung einer Kontamination erheblich.
Hefepilze vermehren sich v.a. direkt an der Tränkestelle in darin gärenden Futterresten. Nur selten besiedeln Schimmelpilze defekte Wasserleitungen.
Physiko-chemische Parameter
| Parameter | Orientierungswert nach BMEL |
| pH-Wert | > 5, < 9 |
| elektrische Leitfähigkeit | < 3000 µS/cm |
| lösliche Salze gesamt | < 2,5 g/l |
| Oxidierbarkeit | < 15 mg/l |
Quelle: BMEL: Hygienische Qualität von Tränkwasser. Orientierungsrahmen zur futtermittelrechtlichen Beurteilung
Der pH-Wert beeinflusst nicht nur den Geschmack, sondern viele chemische und biologische Prozesse. Ein stark saurer oder alkalischer pH-Wert wirkt toxisch auf Organismen. Es kann zu Korrosionen im Leitungssystem kommen. Eine Versauerung kann außerdem Schwermetalle mobilisieren, da deren Löslichkeit mit abnehmendem pH-Wert zunimmt. Die elektrische Leitfähigkeit gibt die Summe der im Wasser enthaltenen Salze an. Sie dient dazu, Änderungen in der Wasserzusammensetzung zu erfassen. Zu einer Erhöhung der Leitfähigkeit kommt es beispielsweise durch Eintrag von Abwässern, Düngemitteln, Streusalz oder nahegelegenen Deponien. Ein Maß für die Summe aller im Wasser vorhandenen organischen Stoffe ist der chemische Sauerstoffbedarf (CSB). Er erfasst sowohl ungefährliche Abwasserinhaltsstoffe als auch mögliche Schadstoffe.
Chemische Parameter
Nitrat/Nitrit/Ammonium: Ammonium entsteht beim Abbau von Proteinen und bei der bakteriellen Zersetzung abgestorbener Pflanzenteile. Im Boden und in Gewässern wird es bakteriell zuerst zu Nitrit und dann zu Nitrat oxidiert (Nitrifikation).
Hohe Nitratwerte werden hauptsächlich durch den Düngemitteleinsatz in der Landwirtschaft verursacht. Der Nitratgehalt, der den Pflanzenbedarf übersteigt, sickert ins Grundwasser. Eine weitere Eintragsquelle ist die Emission von Stickoxiden aus der Industrie oder dem Verkehr. Sichtbar wird ein hoher Nitratgehalt beispielsweise an vermehrtem Algenwachstum. Nitrat kann im Körper wiederum bakteriell oder durch enzymatische Umwandlung zum giftigeren Nitrit reduziert werden. Nitrit wandelt Hämoglobin in Methämoglobin um, das keinen Sauerstoff binden kann. Dadurch kommt es zu einem Sauerstoffmangel im Gewebe. Pferde reagieren besonders empfindlich auf Nitrat. Der Orientierungswert des BMEL wird von Experten als deutlich zu hoch für Pferde angesehen (Orientierungswert Nitrat für Kälber und andere Tierarten: < 200 mg/l). Laut Dietbert Arnold (Sachverständiger für Pferdezucht und -haltung von der HK Bremen und Bremerhaven) können bereits 25 – 50 mg/l im Wasser zu einer schleichenden Vergiftung führen, > 50 mg/l sogar eine akute Vergiftung auslösen.
Im Gegensatz dazu haben Pferde eine hohe Toleranz gegenüber Kupfer, weshalb es nur äußerst selten zu Vergiftungserscheinungen kommt. Kupfer kommt natürlicherweise im Gestein vor – in Tränkwasser gelangt es vorwiegend durch kupferhaltige Leitungen.
Zink kommt natürlicherweise als Bestandteil von Erzen vor. Weitere Eintragsquellen sind Industrieemissionen. Zu Vergiftungserscheinungen kommt es nur bei Pferden im Wachstum (> 15 ppm im Trinkwasser). Diese zeigen sich durch knöcherne Zubildungen an den Gelenken, die starke Lahmheiten verursachen. Lahmheiten können auch auftreten durch Gelenkauftreibungen, verursacht durch hohe Fluoraufnahmen. Weiterhin zeigen sich chronische Fluorvergiftungen an schmerzhaften Zahnveränderungen. Natriumchlorid kann über Niederschläge in das Grundwasser geschwemmt werden. Durch den Einsatz von Streusalz und Düngern kann sich der Eintrag wesentlich erhöhen. Auch Kalium gelangt vorwiegend auf natürliche Weise in das Grundwasser. Ist der Kaliumgehalt allerdings sehr hoch, kann dies auch auf fäkale Verunreinigungen hindeuten. Erhöhte Sulfatgehalte wirken sich nachteilig auf den Geschmack des Wassers aus. Sie sind v.a. in torfigen und moorigen Gebieten zu finden, können aber auch aus Düngung oder Verbrennung fossiler Brennstoffe resultieren. Bei mikrobiellen Zersetzungsprozessen kommt es zu Änderungen des Sulfatgehaltes.
Toxische Stoffe
Blei gelangt beispielsweise über die Verbrennung fossiler Brennstoffe, Munition oder auch alte Wasserleitungen in das Tränkwasser. Es reichert sich im Organismus an, ist neurotoxisch und führt beim Pferd häufig zu Anämie, Störungen des Gastrointestinaltrakts, Lahmheiten, Dyspnoe, Kehlkopfpfeifen, Aspirationspneumonie. Jungtiere sind empfindlicher als adulte Pferde.
Arsen stammt hauptsächlich aus der Metallindustrie und Kohleverbrennung. Früher war es in vielen Schädlingsbekämpfungs- und Pflanzenschutzmitteln enthalten. In bestimmten Gebieten kann es auch auf natürlichem Wege in das Grundwasser gelangen. Je nach aufgenommener Dosis kommt es zu akuten oder chronischen Vergiftungen. Cadmiumvergiftungen verlaufen i.d.R. chronisch; es kommt v.a. zu Nieren- und Skelettschäden. Neben einem Eintrag aus der Industrie ist es auch in Klärschlämmen und Düngemitteln enthalten. Quecksilber verursacht in erster Linie neurologische Schäden. Die Eintragsquellen ähneln den vorgenannten, zusätzlich ist es auch in Saatbeizmitteln vorhanden.
Technologisch störende Stoffe
Calcium und Magnesium bestimmen die Wasserhärte. Kalk setzt nicht nur Leitungen zu, sondern beeinflusst auch die Schmackhaftigkeit des Wassers negativ. Auch Mangan und Eisen können sich nachteilig durch Ablagerungen auf die Trinkwassertechnik auswirken. Eisen beeinträchtigt zudem den Geschmack des Wassers, was dazu führen kann, dass zu wenig Wasser aufgenommen wird. Eine hohe Eisenaufnahme über einen längeren Zeitraum kann beim Pferd zu Hämochromatose und Leberschäden führen.
Fazit
Um Pferden genügend Wasser in geeigneter Qualität anbieten zu können, kommt es auf die Tränketechnik und das Haltungsmanagement an. Regelmäßige Wasseruntersuchungen geben Aufschluss darüber, ob das Tränkwasser die entsprechende Qualität aufweist. Welche Untersuchungsparameter für die jeweilige Pferdehaltung wichtig sind, hängt von vielen individuellen Faktoren (geographische Lage, Industrienähe, Intensität der Landwirtschaft, Tränketechnik, Art der Wasserquelle etc.) ab. Hier stehen wir sehr gerne für eine persönliche Beratung bereit.
Ann-Kathrin Schieder
Dr. Martin Felten